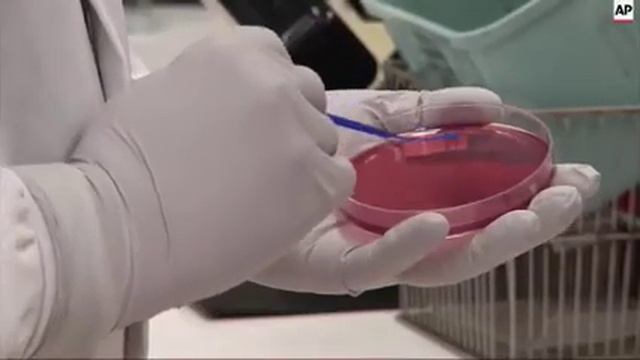
More Chipotle E. Coli Cases in Pacific Northwest смотреть онлайн

Автор / Канал: Музыкальное совершенство Страница 8

Granny Chapter 2 OST: Helicopter Escape
![Villoldo: El Choclo, for Violin & Piano (arr. Birtel) - Piano Part [Fast Tempo] смотреть онлайн Villoldo: El Choclo, for Violin & Piano (arr. Birtel) - Piano Part [Fast Tempo] смотреть онлайн](https://pic.rtbcdn.ru/video/dc/d6/dcd6aa61048a13ee9af653cb8926b7e6.jpg)
Villoldo: El Choclo, for Violin & Piano (arr. Birtel) - Piano Part [Fast Tempo]

Ocarina of Time Battle Theme on Guitar

YAMAHA CLAVINOVA CLP-635 Product Demonstration Video

Yann Tiersen - La Valse d'amelie Piano

Star Wars Rise of Skywalker Final Trailer | -PIANO COVER-

DALI JE OVO MOGUĆE/CLSH ROYALE/#9
![[HCM021] Dàn 35trd Hướng dẫn chỉnh Mixer Soundcraft EFX8 cho Bộ Tứ Siêu Đẳng смотреть онлайн [HCM021] Dàn 35trd Hướng dẫn chỉnh Mixer Soundcraft EFX8 cho Bộ Tứ Siêu Đẳng смотреть онлайн](https://pic.rtbcdn.ru/video/c8/5e/c85e4dfd25a69391c51e17cb7b676243.jpg)
[HCM021] Dàn 35trd Hướng dẫn chỉnh Mixer Soundcraft EFX8 cho Bộ Tứ Siêu Đẳng

Prayer!! sing them over again to me!!With my students!! Pawan Sharma

Geometry Dash - Stereo Madness - Note Block Cover

Song to the moon from Rusalka by Dvorak - ETHEREAL - (Piano solo by Matthias Dobler)

To the moon~ For River ||extended Johnny's version♥

Первый раз выпало зеркало в клэш

Задонатил 2000 гемов. Артем тратит гемы в BRAWL STARS. Покупка бравл паса.

abs test | bullet | royal enfield classic 350 cc | abs | 2018 | bs4 | review

ROYAL HALL

TOP 4(SECRET ) CLASH SQUADCHARACTER SKILL" COMBO ) || free firebest combination

Clash Royal тактика наподения 2 и 3 арены 2атака была с другом

Lets Play F2P Clash Royale #1: Beast Noob Deck
![Cake 17.05.2014 [#4]: [Arma III: Battle Royale] Goodoq смотреть онлайн Cake 17.05.2014 [#4]: [Arma III: Battle Royale] Goodoq смотреть онлайн](https://pic.rtbcdn.ru/video/c4/47/c44709ac279e6cd2b36ebad8b266a110.jpg)
Cake 17.05.2014 [#4]: [Arma III: Battle Royale] Goodoq

ИГРАЮ РАЗНЫМИ КОЛОДАМИ/Clash Royale

.ЛОКАЛКИ МЕТРО РОЯЛЬ . УЧИМСЯ ИГРАТЬ В МЕТРО РОЯЛЬ .

If you play iceworld in CS2D
More Chipotle E. Coli Cases in Pacific Northwest
За каждым успешным каналом стоит личность, идея и сотни часов кропотливого труда. Если вы здесь, значит, автор «Музыкальное совершенство» уже сумел зацепить ваше внимание своим уникальным стилем или подачей. А мы на RUVIDEO позаботились о том, чтобы вы могли изучить весь архив его работ в максимально комфортных условиях — без лишней суеты и преград.
Почему за работами канала «Музыкальное совершенство» так интересно наблюдать? Всё просто: это честный контент, который находит отклик в сердцах зрителей. На нашем ресурсе вы можете смотреть онлайн все видео любимого автора бесплатно и в хорошем качестве. Нам важно, чтобы вы видели каждую деталь и слышали каждый нюанс, поэтому мы используем только стабильные плееры из открытых источников Rutube.
Следите за новинками канала, пересматривайте старые шедевры и открывайте для себя новые грани творчества «Музыкальное совершенство». Мы постоянно обновляем ленту, чтобы у вас под рукой всегда были самые свежие выпуски. Никаких сложных регистраций — только вы и творчество, которое вдохновляет. Приятного вам путешествия по миру авторского контента на RUVIDEO!
Видео взято из открытых источников Rutube. Если вы правообладатель, обратитесь к первоисточнику.